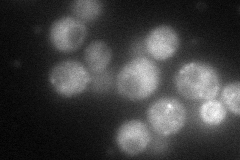
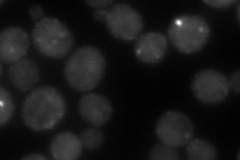
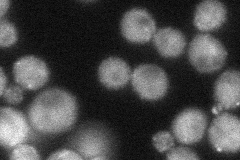

View description
Epsin-like protein required for endocytosis and actin patch assembly and functionally redundant with Ent1p; contains clathrin-binding motif at C-terminus
Localization:
Intensity:
Fold change:
Significance:
-
C’ GFP library in SD

below threshold16.55 -
N' NOP1pr-GFP in SD
punctate94.8729 -
N' TEF2pr-mCherry in SD
punctate108.307 -
N' NATIVEpr-GFP in SD
punctate46.0958 -
N' TEF2pr-VC and Cyto-VN in SD

cytosol,punctate43.8571 -
C’ GFP library in SD+DTT

cytosolN/AN/ANo -
C’ GFP library in SD+H2O2

cytosolN/AN/ANo -
C’ GFP library in Starvation Media

cytosolN/AN/AYes -
C’ GFP library on the background of Pup2-DaMP

below threshold -
C’ GFP library on the background of CCT mutant

below thresholdN/AN/ANo
